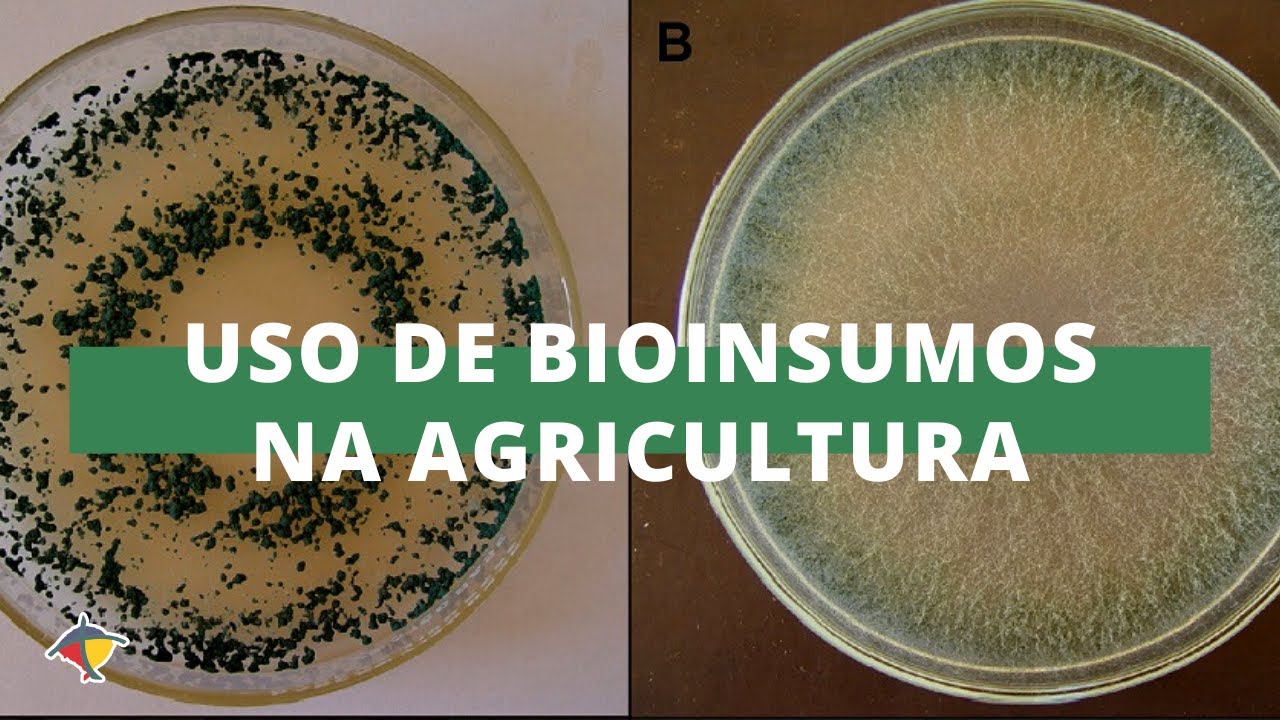
Uso de bioinsumos na agricultura reduz custos e impactos no ambiente | Programa Terra Sul

[Música] [Aplausos] Vamos iniciar então com o nosso primeiro painel do dia de hoje a temática Bio insumos em Sistemas produtivos para iniciar essa nossa conversa sobre agricultura sustentável nós vamos convidar ao palco aqui Bruno ranhofer da Fazenda Campo Bonito aqui em Guarapuava que falará sobre a sua experiência com o uso de bio insumos primeiro explicar um pouquinho de grupo em offer então Aqui é do grupo ranhof só para a gente se localizar cidade de Guarapuava tem são é um grupo familiar é eu meu irmão é subdividido entre as fazendas e as unidades de negócios o
pai e até a mãe faz a parte toda social do grupo então é cidade de Guarapuava Fazenda cupim fazendo em Santa Isabel fazendo a Santa Bárbara fazendo Invernada reserva e na Fazenda Campo Bonito é o que eu vou focar mais na palestra onde é que eu tô mais no dia a dia isso sou responsável Então hoje no grupo 56% da área total agricultura 39% são florestas em torno de um por cento é sérios estradas enfim benfeitorias e quatro por cento e florestamento tanto eucalipto como pinos estão explicando só no slider na região acredito que a
grande maioria é Talvez seja aqui de regiões próximas ou até de outros estados só para exemplificar como aqui tenha essa variabilidade então no grupo tem talhões que vão de 1350 metros é o título até 855 e uma média aí de 2100 milímetros ano que é uma médica eu peguei aqui da fundação a grade pesquisa FAPA são de 30 anos e o histórico de temperatura de Janeiro a Dezembro Então faz frio que nem preciso falar pela época tão percebendo há 10 anos atrás até teve uma uma leve Neve depois de 40 anos então realmente o inverno
ele proporciona essas temperaturas mais baixo próximo slide para não tentei resumir o máximo aí a questão química do solo que o grupo acredita muito historicamente já nascens do solo acho que agricultura teve essa pesquisa e foi muito bem e tá sendo um grande diferencial a nível Mundial que é realmente a questão química ela tem tem sido estudada e tem sido aplicada na prática a gente conhece muito bem como a química e a física e hoje talvez seria uma uma terceira onda que seria a questão da microbiologia do solo que ainda é um pouquinho mais desconhecida
comparando essas essas duas então aqui são pelas fazendas não vou até pelo tempo eu não vou discorrer item a item ali mas acredita os principais ali PH por fazenda então a média do grupo em torno de 5.5 isso valendo que vou explicar mais para frente mas a rotação como é Milho um terço e soja é dois terços cada terceiro ano entrou o calcário então fica sempre dois anos sem calcário e no terceiro ano entre o calcário Então essa é uma média já no terceiro ano pré aplicação calcário então nas culturas mesmo CPH fica acima ou
fósforo em torno de 11 de média aí potássio também acredito que vale a pena citar o 04 a gente busca o 05 ainda não atingimos elas são cálcio magnésia entre três e quatro hoje também três enfim e a composição do solo na média 65% de argila 25% de 10% de areia em termos a microbiologia do solo aqui embaixo nessa nessa planilha a gente começou a fazer a um para cima de mim tem um ano um ano e meio a gente hoje tem mais dados do que informações e aqui estão alguns números por fazenda mais ali
o seu fatase Beta glicose que a gente acredita que são essas enzimas que hoje a gente é tem um como um bom padrão de comparativo mas Igual eu falei como tá no início o grupo tem três anos de experiência muito pouco na minha opinião três anos de experiência na questão de uso de biológicos ativo mesmo na prática Então a gente tem mais coletado dados e tentar conectar pontos nessa questão daria o seu fantasma para fazer esses comparativos tanto de manejo como de produtividade e qualidade dos produtos aqui um exemplo só puxando um pouquinho mais detalhado
acho que depois vai ter até a oportunidade de perguntas podemos detalhar mais ainda mas a gente fez em três talhões do grupo esse FC um Piquete ele é um digamos assim um pedaço de um talão em torno de 30 hectares aonde o grupo sempre produz mais bem mais às vezes até eu dou chega o dobro da produção e a gente ainda não consegue entender porque quimicamente ele não é muito diferente de outras talhões inclusive detalhões do lado e a gente não consegue entender Talvez um dos Ganchos sejam dos gargalos seja para essa parte biológica da
gente conseguir externalizar isso estender para os outros talhões em comparação por exemplo FC normal que é o talão mesmo normal então aqui na e o seu fantasma a gente vê que tem um número maior na Beta visgosidade menor e a gente colocou como item Floresta só para a gente ter como não vou nem usar dizer comparativo porque é um estado de Equilíbrio e a gente acredita na agricultura tanto químicamente fisicamente biologicamente a gente já faz um outro rearjo né a própria adubação é eu diria um exemplo disso porque em Floresta não tem nutrientes solúvel então
só o fato da gente de adubar já tem um re arranjo um novo estado de Equilíbrio nessas nessas áreas mas ele serve não talvez não vou dizer como parâmetro mas como um número de algum tipo de comparativo a floresta ficou muito próxima a esse do Piquete na questão fantasma Porém na Beta é perigosidade até ficou abaixo então por isso que a gente tem tem quebrado a cabeça e tem estudado um pouquinho sobre esses números e aí portalhões mas volta a dizer não vou discorrer por ano ou portariam aqui em função do tempo né Mas aí
tem a questão as diferenças que tem vocês podem perceber que tem talhões que tem muito abaixo por exemplo tá ali um reserva talião um 127 e tem talhões muito acima se tá aí um talião que é Santa Bárbara com 352 e se você fizer um link com produção e às vezes até ele tem uma uma conexão maior com qualidade do que com produção ele eu diria uma correlação de 70 80% ele bate Então tem muito ainda que eu evoluir Mas eu acredito que é um é um belo uma bela de uma ferramenta hoje que a
gente tem explicando um pouquinho da rotação de Cultura que deve ser falado aí durante os dois dias de evento mas a questão da rotação de Cultura ele vem muito na importância do plantio direto que talvez seriam os três pilares né não mexendo no solo e sempre a cobertura né e aqui são os vários tipos de exemplo o que que o grupo faz então A grande maioria não tomar o que nós estamos agora nesse período a veia preta e nabo a gente fez em alguns talhões esse ano algum uma experiência com uma veia vem sentei a
ervilhaca aveia ervilhar e também outros outros anos também com os Mix e também alguma coisa assim outonow o grupo esse ano até vai começar na linha do Hortifruti e ali ficou digamos assim como fosse uma testemunha ficou uma uma parcela de área sem otonal aí o cultivo da cevada no grupo muito forte acredito na região [Música] 2.836 hectares 1530 uma coisa senteio aí já vamos para o verão entre milho 3 militares soja cedo que a gente fala cedo é onde é que não vai nem cevada nem trigo aí o plantio digamos assim seria a partir
do dia 10 de outubro mais ou menos e a soja soja normal seria uma uma soja pós cevada e trigo que é a segunda quinzena de outubro dependendo do ano vai ir vai até o final de até o dia 20 30 de novembro escorrer bem rápido aí só algumas fotos essa é a questão já começa tudo ao planejamento e apicultura ou exemplo da veia preta nessa fase tanto da Via preta e do da questão do período do ano o grupo utiliza muito a questão do tbt mais para frente Vou mostrar então quando entra nessa fase
aí ele ele entra 100% puro tbt Sem Limites por etária e de uma duas aplicações dependendo do ano então é sempre pré-cultura comercial Ou logo após o plantio da cultura comercial nesse caso agora davam a preta seria humilha né outra foto seria essa do nabo forrageira que eu citei antes então o nabo ele entra Após Mim e também com o uso de tbt e muitas vezes o tricoderma tricoderma mais até na soja do sedo do que no nabo mas no nabo ele também tem um planejamento de entrada e o nabo Geralmente vem pós milho e
aí pós na abovem a cevada então ele sempre fica coberto e o porque pós milho a gente tem percebido que ele auxilia junto com tnt na degradação da Palhada do milho e com Isso facilita além da degradação facilita o plantio então aqui são alguns exemplos ele ele não tem um estágio tão avançado diria assim que até nessa foto aqui que tem a floração lá até dependendo a época ali ela já passou até um pouco do ponto na dissecação poderia ser ressecado até antes e se deixar você via flor o manejo Talvez um pouquinho mais intensivo
tricoderma visando lá na frente na soja ou mofo branco antes correr um pouquinho do tbt que próprio Professor Tomita tá aí deve estar presente a gente aprendeu muito com ele visitou auxiliou nós até na estrutura aqui um pouquinho de foto que é o de sol de Mata acredito que ontem até teve uma um minicurso específico disso a gente até fez essa essa questão do teste da do arroz e eu diria assim até um convite é os produtores que muita gente ainda tem esse receio Nós também tivemos e até visitas fora do país a gente percebe
produtor independente em país é tudo igual a gente só acredita mesmo fazendo e em casa não é nem numa instituição de pesquisa e vendo né então a gente tem vários exemplos Isso aí foi um gosta de citar essa questão do Arroz porque se você colocar o arroz em Bambu em qualquer talento um talão talvez Escolhido um dos dos melhores e numa floresta você vê exatamente a diversidade que tem num local e no outro aí começa já um caminho para enxergar o porquê da multiplicação né Isso também puxar um pouquinho na história acredito que lá em
2000 a gente Conseguiu perceber que um por cento dos microrganismos a gente consegue multiplicar em medo de Cultura Então até ali a gente não praticamente enxergava nada hoje a gente tá começando a enxergar a própria tbt a gente tem um desafio dentro do grupo de tentar replicar o máximo possível tem uma qualidade melhor dele porque igual a própria terra que é usada é seria impossível o que a gente tenta fazer é trazer essa diversidade que tem hoje na floresta é maior no campo multiplicação um breve resumo até uma foto aí da Fazenda Santa Bárbara onde
é que começou há três anos o primeiro experimento Então a gente tem um medo cultura até o grupo desenvolveu aí um ano e meio de estudo e enfim pesquisa tem um laboratório na Fazenda Campo Bonito que eu vou mostrar nos Light mais à frente e desenvolver um meio de Cultura própria interno aí a Cepa é comprada e a questão da água e o custo hoje né Coloquei até embaixo Aqui a regulamentação da produção de insumos isso é mais deixar Sempre dito que a gente faz tudo dentro das normas e das leis não tem nada fora
de sair modo de ação dos micro-organismos eu não vou meter ali Acho que durante esses dois dias vai ser comentado bastante mas seria o antagonismo que a gente espera ou parasitismo dependendo qual microrganismo de que vai ser multiplicada competição de resistência aqui eu tbt numa das propriedades dessa Fazenda aí tem 250 hectares de lavoura faz até meter próprio que seria nessas estruturas tem seis e B6 de mil litros e um tanque de 10 mil litros de estoque mas também com com aeração aí os produtos que hoje a gente consegue ter acesso e também remodelou que
talvez seria um comentário muito bom no começo a gente colocou menos farinha menos diversidade e farinhas e mais quantidade e o que a gente viu via laboratório que é melhor você diminuir essa quantidade mas aumentar a diversidade Então em vez de só ter farinha por exemplo de trigo é 10 kg é melhor ter farinha de trigo 5 kg e farinha de peixe 5 kg percebeu que nas placas ali a diversidade é muito maior então comidas diferentes enfim bocas diferentes vai resultado fica melhor e o custa também ali você custa em torno de dois meses atrás
fiz uma última atualização na última compra mas escova me dando mais não deve fugir muito disso aí a inoculação hoje é muito bem vista pelo grupo e trabalhada 100% das máquinas têm inoculador tanto o inverno como no verão e na inoculação a gente usa praticamente só isolados isolados tanto comerciais Asus pirilam e bradison uma pelo custo e a segunda é porque via um fárma ele é um pouquinho mais sensível para você fazer a produção e o restante ou um fárma aqui duas fotos uma até fazendo Santa Bárbara outra da Campo Bonito um exemplo de inoculador
esse no caso é 900 litros aquele da foto da plantadeira é 1.500 litros nos plantios é em torno de 60 a 65 litros de evasão por etária e quando usa usam Farm é quatro litros por Itália Então hoje o grupo usa por experimentos em parcela ou megatério a mina o que faz pummos que também um exemplo que eu gosto sempre citado o professor do Thomas lá do Rio Grande que ele colocou até os diferentes tipos ali e na veia a diferença que deu né isso acredito que seja em vaso né mas é um bom um
bom de olhar um bom experimento ali de ver as diferenças que podem ocasionar [Música] e só uma um slide não vou meter muito mas hoje como tem no químico tem na questão dos biológicos também várias empresas com vários manejos nós no grupo fazemos as nossas via parcelas e acreditamos que com os erros e assim erros e acertos a gente consegue fazer um manejo próprio mas é só para exemplificar que hoje já existe então no começo do zero acho que começa daqui você vai começando a alinhar e ver o que que realmente tem dado resultado na
propriedade então experiência do grupo que um talão de 250 hectares a gente fez 120 dá para ver bem pela cor mais clara só biológico a gente forçou essa situação até para sempre brinca até para acreditar na tecnologia que nem eu falei antes produtor Acredita quando ele vê e a gente fez um sistema intensivo nesse sentido infectares porém aí também vem um comentário que a gente aprendeu na prática que hoje o grupo utiliza muito na potencialização é tanto da produção como da qualidade porém em outro lado nesse experimento a gente teve um erro grave a gente
usou Asus pirilam e retirou ureia então diria assim na substituição hoje principalmente no começo tem que ser tomar muito cuidado a gente fez esse erro viu até aplicou depois nessa foto não vai ficar nítido mas aí dá para ver que foi Coreia duas a três semanas depois do time e e tanto na cevada como depois na soja deu para ver a diferença do erro essa produção foi a menor e a gente acredita que muito pela ureia até porque a ureia fora de época ela já encostou mais na produção padrão digamos assim química então foi a
primeira experiência Nossa numa cevada em e igual eu comentei aqui tem não vou discorrer de novo função do tempo já tá encaminhando no final mas assim tem todas as aplicações em torno de sete a dez dias todas as entradas com isolados e nessa nesse talão específico não é hoje o manejo nem nem tem hoje a receita do grupo de bolo do grupo mas assim nessa como foi forçada e nesse ano que talvez até a pressão foi um pouquinho Menor Ela conseguiu fechar o Ciclo Sem nenhuma sem nenhuma intervenção química não sei dos herbicidas então tem
todas as aplicações aqui do lado né eu comentei essa cevada variedade Danielle cervejeira aí a gente fez um outro teste aí Emília não beijei 24 a 18 com três aplicações etmt 20 litros por etária que Vale ressaltar que humilha a gente fez um teste e deixou ele por três meses tanto biológico químico e a degradação do Milho químico foi muito mais rápido que o biológico então parece que o biológico tem uma proteção uma capa que na degradação dele ele demora muito mais armazenar seria um pouquinho melhor nesse sentido aqui um trigo turu que foram tbt
duas aplicações em 20 litros aqui junto com o químico por isso que até foi retirada que as partes que é o químico aqui uma soja Zeus acredito que uma das mais plantadas na região também teve uma uma experiência com subtíveis um pouquinho melhor porque ela ela não engalha tanto mas em outras sojas que engalha que a questão do índio hoje é no biológico a gente tem sofrido muito que no químico é bem tranquilo digamos assim relativamente tranquilo comparado a mofo a ferrugem Mas a questão do índio realmente é Um Desafio na questão biológico inclusive nos
testes internos do grupo a gente tá vendo mais eficiência sempre preventivo de um choro de leite do que qualquer outro qualquer outra Cepa ou o produto biológico mesmo a última já escorrendo Mas vai ser sobre o feijão o feijão também eu diria assim que para começo até seria uma sugestão para fazer essa questão de de manejo químico biológico a gente conseguiu fazer ele com uma entrada bem na época da floração de química e levando até nisso aí só com isolados às vezes com uma entrada junto com o TNT de 5 a 15 litros de por
etária de TNT e no restante após a floração também até o final do ciclo que tem anos aí que a pressão um pouquinho maior realmente só com uma fica um pouquinho mais difícil mas no geral sem o biológico a gente viu que seria talvez de três ou até em situações mais mais complicadas quatro aqui também não vou discorrer tanto mas só para aceitar a temperatura PH brinque se limpeza principalmente na questão dos isolados a gente tem visto que que é primordial esse esse monitoramento até para ter um produto de qualidade então quando a gente produz
pelo menos contaminantes e concentrações no grupo sempre é sempre avaliado para entender pelo tempo também não vou discorrer tanto mas aqui eu puxei só um problema a mancha na questão da cevada a gente colocou em placa e aqui é só para ver a rapidez que isso aí se transforma aqui a gente fez com tbt duas bateladas três até 12 a gente já fez um comparativo Até 14 mas a gente viu que até sete ele tem um comportamento muito bom inclusive de três na terceira até a sétima onde é que é maior biodiversidade existe principalmente em
questão de de fungos aqui só as diferenças entre entre a mancha com amilo com sultines com até com Blend entre eles mas as diferenças entre os crescimentos por exemplo com a Mila ele teve um pouquinho mais facilidade por exemplo comparado com pomelos enfim aí a conversa vai longe até porque a gente tem essa Cepa desse ano da Mancha né hoje a gente já tem conhecimento e tem mais de 50 tipos de raça de mancha então tem ano que até no químico também tem ano que funciona um produto é melhor que o outro e aí esses
testes são muito importantes diria assim qualidade de solo também a produtores dois que acreditam vale a pena dimensionar que é o raiz ou a raizamento tanto em quantidade quanto sanidade é um sensor Claro e direto que a Biologia tá indo muito bem e a outra questão é da fitotoxidada Então como a maioria dos Químicos são biodegradáveis a gente acredita que quando tem muita fito produtor já pode desconfiar que a questão biológica talvez não esteja tão boa na sua área Não tá passando ainda aqui só do grupo das trocas e informações acredito que esse seja mais
importante aqui é o próprio simpósio é uma extensão e acredito que aí é o grande ganho nessa troca de ideias e informações o grupo também faz essa aqui são de inoculações parcelas que até o agrônomo o Venício hoje o grupo tem um agrônomo com foco telemetria mas também auxilia nas decisões de aplicações os diferentes pós estudos tanto químico como biológicos nos inverno aqui a questão o grupo fez o primeiro ano dessa dessa questão do sequenciamento genético mas volta de tem mais dúvidas do que respostas mas já é o primeiro ano a gente viu em três
talhões a diferenças que tem e São várias desde promotores de crescimento até reguladores até indução de resistência enfim hoje tecnologias disponíveis tem aqui tem até o próprio aplicativo de de bio insumos para quem quer e um pouquinho mais além diria hoje no grupo também o desafio São a reestruturação organizacional pelo horário da aplicação por químico você já tem um produto pronto ou biológico tem a questão da produção então mudança cultural dentro não é fácil não é rápido mas ela é possível um entendimento maior tentando aprender no próprio simpósio é um exemplo disso aí e nas
práticas a gente tem visto o dia a dia que é muito mais desafiador que quando você começa quando você acha né que entender um pouquinho da questão da biologia do solo e a pesquisa eu acho que sem dúvida é o grande caminho principalmente regionais Então hoje a gente tem aqui a FAPA fundação da grape pesquisa a gente tem também perto ABC Fundação ABC acho que já estão trabalhando nesse sentido certificações do grupo só citar hoje é rts e o próprio biológico vem de encontro nisso uma tendência futuro a gente acredita até rodando fora do país
tem ganhado cada vez mais força é o crédito carbono o resíduo químico nos produtos o uso de água que é da biofábrica a gente tem essas coletas de água via chuva Bill herbicida esse ano o grupo já tem uma parceria vai fazer alguns testes também acredito que seja um grande divisor de águas na questão do manejo a gente acredita também na questão do índice diesel consumo de diesel por Tonelada até para a gente se comparar muitas vezes com produtores fora do país a competir competitividade nossa pode passar indo para o final já tô misturado no
tempo queria agradecer que a gente não aprende nada sozinho e agradecer aqui o até o Vinícius a nossa agrônoma aqui do grupo o Celso deve estar aí no evento o Fernando andreoti tem dado um apoio e muita informação muita ideia muito importante fundamental a Ieda até principalmente na questão das enzimas que eu citei Rodrigo Mendes também da da Embrapa tem feito um trabalho hoje até nos Estados Unidos tem feito um trabalho muito bom agrária via pesquisa também hoje já tem uma área de biológicas professor toma se tem Brenner Eu Acredito que esteja aí também aprendeu
bastante até com estruturas e o próprio gás né que tem alavancada essa essa questão aqui no país e que acho que até referência fora do Brasil para outros produtores tem essa organização que hoje existe aqui alavancar isso mais mercado nem vou discorrer é o mercado que mais tá crescendo também deve ser visto aí nos próximos dois dias pode passar empresas também isso até eu gosto sempre de citar o próprio produto aí da Baia Então as empresas estão correndo atrás e sabem disso sabe que tem resultado Só que também não é fácil virar a chave de
uma hora para outra né mas portanto que pesquisas estão acontecendo e o pessoal tá vendo mesmo num cenário um pouquinho digamos assim nebuloso mais resultados existem então aparecendo então meu muito obrigado desculpa ter estourado pouco tempo aí [Aplausos]